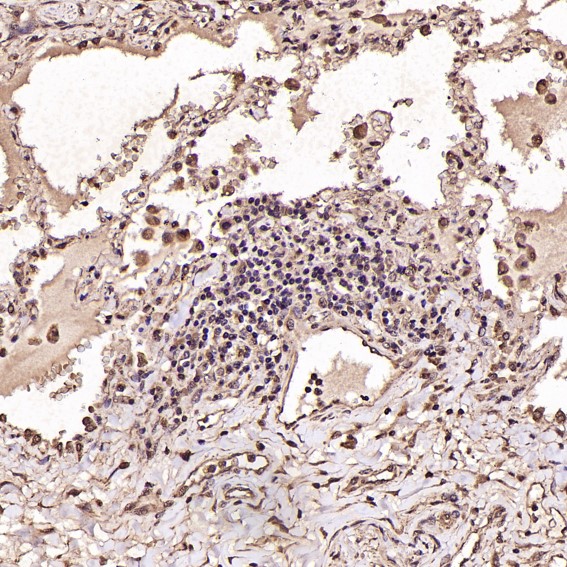

单克隆抗体
BDNF Antibody (CY5230)
References (1)
UniProt:P23560
Application:WB,IHC,ICC/IF
Reactivity:Human,Mouse,Rat
Source:Rabbit mAb
BDNF Antibody (CY5230)
UniProt:P23560
Application:WB,IHC,ICC/IF
Reactivity:Human,Mouse,Rat
Source:Rabbit mAb
References(1)
http://www.abways.cn/showproduct.asp?cid=CY5230
PTEN Antibody (CY5231)
References (2)
UniProt:P60484
Application:WB,IHC,ICC/IF,FC
Reactivity:Human,Mouse,Rat
Source:Rabbit mAb
PTEN Antibody (CY5231)
UniProt:P60484
Application:WB,IHC,ICC/IF,FC
Reactivity:Human,Mouse,Rat
Source:Rabbit mAb
References(2)
http://www.abways.cn/showproduct.asp?cid=CY5231
Phospho-EGFR (Y1092) Antibody (CY5232)
UniProt:P00533
Application:WB,IHC,ICC/IF
Reactivity:Human,Mouse
Source:Rabbit mAb
Phospho-EGFR (Y1092) Antibody (CY5232)
UniProt:P00533
Application:WB,IHC,ICC/IF
Reactivity:Human,Mouse
Source:Rabbit mAb
http://www.abways.cn/showproduct.asp?cid=CY5232
Met (c-Met) Antibody (CY5233)
UniProt:P08581
Application:WB,IHC,ICC/IF,FC
Reactivity:Human,Mouse,Rat
Source:Rabbit mAb
Met (c-Met) Antibody (CY5233)
UniProt:P08581
Application:WB,IHC,ICC/IF,FC
Reactivity:Human,Mouse,Rat
Source:Rabbit mAb
http://www.abways.cn/showproduct.asp?cid=CY5233
Calmodulin Antibody (CY5234)
UniProt:P62158
Application:WB,IHC,ICC/IF,IP,FC
Reactivity:Human,Mouse,Rat
Source:Rabbit mAb
Calmodulin Antibody (CY5234)
UniProt:P62158
Application:WB,IHC,ICC/IF,IP,FC
Reactivity:Human,Mouse,Rat
Source:Rabbit mAb
http://www.abways.cn/showproduct.asp?cid=CY5234

销售咨询
一键电话